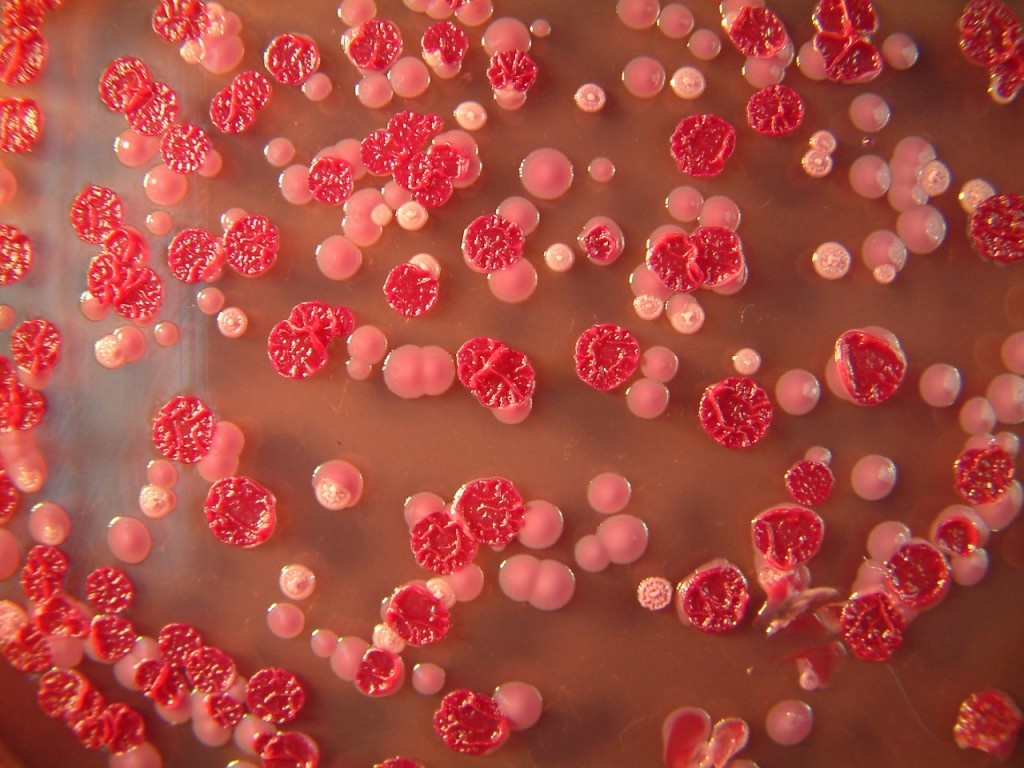
Whitmore anh 4

|
Whitmore là bệnh lây nhiễm gây ra bởi vi khuẩn?
Theo bác sĩ Nguyễn Thị Huyền Ngân, khoa Tai Mũi Họng, Bệnh viện Sản Nhi Nghệ An, Whitmore là bệnh lây nhiễm gây ra bởi vi khuẩn Burkholderia pseudomallei, gây nhiễm trùng máu. Bệnh không có triệu chứng rõ ràng và dễ nhầm lẫn với nhiều bệnh khác, có thể gây tử vong nhanh chóng. Tỷ lệ tử vong của bệnh Whitmore có thể lên đến 50-60%. |
 |
Bệnh Withmore không lây từ người sang người?
Theo PGS.TS Bùi Vũ Huy - Giảng viên cao cấp bộ môn Truyền nhiễm Đại học Y Hà Nội, Cố vấn khoa nhi, Bệnh viện Bệnh Nhiệt đới Trung ương - Whitmore đang bị hiểu lầm là vi khuẩn "ăn thịt người". Whitmore hoàn toàn không phải là bệnh truyền nhiễm lây từ người sang người khi tiếp xúc nói chuyện. Đó cũng không phải là virus ký sinh trên động vật, thực vật và con người. Đây chỉ là căn bệnh nhiễm trùng cơ hội, không dễ mắc, ít gặp ở người có sức khỏe bình thường. |
 |
Vi khuẩn Whitmore thường được tìm thấy ở?
Vi khuẩn whitmore gây bệnh được tìm thấy trong đất, đồng lúa và các vùng nước tù đọng. Người nhiễm bệnh thường tiếp xúc với đất bị ô nhiễm qua các vết trầy xước ngoài da hoặc hít phải bụi nhiễm vi khuẩn. |
|
Ca mắc Whitmore đầu tiên trên thế giới được phát hiện ở?
Theo Independent, năm 1927, ca mắc Whitmore đầu tiên được phát hiện tại Sri Lanka. Ban đầu, các bác sĩ điều trị bệnh bằng lửa, sau đó là kháng sinh. Nhưng kết quả vẫn có 50% bệnh nhân tử vong sau khi phát hiện mắc bệnh. Hiện vẫn chưa có thuốc đặc trị căn bệnh này. |
 |
Bệnh nhân không được điều trị kịp thời sẽ gây ra?
Theo PGS.TS Bùi Vũ Huy, Giảng viên cao cấp bộ môn Truyền nhiễm Đại học Y Hà Nội, Cố vấn khoa nhi, Bệnh viện Bệnh Nhiệt đới Trung ương bệnh nhân không được điều trị kịp thời bằng thuốc kháng sinh sẽ gây ra hoại tử các tổ chức. |
 |
Đối tượng nào dễ bị vi khuẩn Whitmore tấn công?
Những người có bệnh tiểu đường, bệnh gan, thận, phổi mạn tính, suy giảm miễm dịch cần được chăm sóc, bảo vệ các vết thương để ngăn ngừa nhiễm khuẩn. Những người có cơ địa yếu, sức đề kháng kém, nguy cơ nhiễm bệnh càng cao. Đối với những bệnh nhân này, vi khuẩn sẽ dễ dàng xâm nhập vào cơ thể bởi sức đề kháng của họ đã suy giảm, khó có khả năng phản ứng tốt với vi khuẩn. |
 |
Khi có vết thương hở, vết loét hoặc vết bỏng cần lưu ý điều gì?
Theo khuyến cáo của Cục Y tế dự phòng, Bộ Y tế, khi có vết thương hở, vết loét hoặc vết bỏng cần tránh tiếp xúc với đất hoặc nước có khả năng bị ô nhiễm. Nếu bắt buộc phải tiếp xúc thì sử dụng băng chống thấm và cần được rửa sạch đảm bảo vệ sinh. Ngoài ra, người dân nên sử dụng đồ bảo hộ lao động (giày, ủng, găng tay…) đối với những người thường xuyên việc ngoài trời, tiếp xúc với đất, bùn và nước bẩn. |
 |
Cần làm gì để phòng tránh lây nhiễm Whitmore?
Cục Y tế dự phòng, Bộ Y tế khuyến cáo người dân cần thực hiện các biện pháp: hạn chế tiếp xúc trực tiếp với đất, nước bẩn, đặc biệt tại những nơi bị ô nhiễm nặng. Không tắm gội, bơi, ngụp lặn ở các ao, hồ, sông tại/gần nơi bị ô nhiễm. Đồng thời, sử dụng đồ bảo hộ lao động (giày, ủng, găng tay…) đối với những người thường xuyên việc ngoài trời, tiếp xúc với đất, bùn và nước bẩn; thường xuyên rửa tay với xà phòng và nước sạch, đặc biệt là trước và sau khi chế biến thức ăn, trước khi ăn, sau khi đi vệ sinh, sau khi đi làm ruộng. Ngoài ra, cần tuân thủ ăn chín, uống chín, đảm bảo vệ sinh an toàn thực phẩm; không giết mổ, ăn thịt động vật, gia súc, gia cầm bị ốm chết. Khi nghi ngờ nhiễm bệnh cần đến cơ sở y tế để được tư vấn, khám phát hiện và điều trị kịp thời. |


